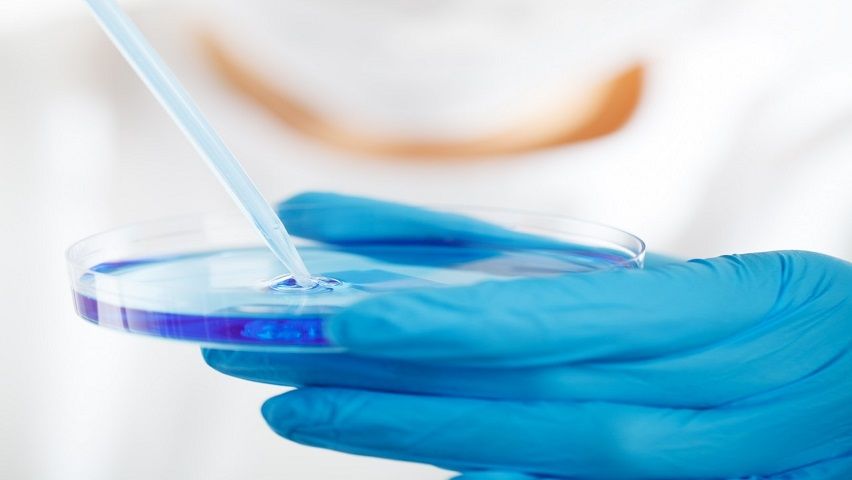
image

PIH Health Patient Portal | Whittier, CA | PIH Health
20 hours ago PIH Health Good Samaritan Hospital patients, CLICK HERE to access your patient portal. Reasons to Register Manage your healthcare 24/7 from your computer or your mobile device Make or request an appointment Telehealth appointments are available. Watch this video from Follow My Health on how to join a scheduled video visit. >> Go To The Portal
What do I need to use IDPH web portal?
PIH Health Good Samaritan Hospital patients, CLICK HERE to access your patient portal. Reasons to Register Manage your healthcare 24/7 from your computer or your mobile device Make or request an appointment Telehealth appointments are available. Watch this video from Follow My Health on how to join a scheduled video visit.
What is included in the patient portals?
To make a payment, live chat or to send an email, visit us at IMPH.PATIENTBILLHELP.COM. Pay by phone or for questions, dial 844-267-2552. If you have questions regarding how your claim was processed, please refer to your Explanation of Benefits (EOB) provided by your insurance carrier or contact your insurance carrier directly.
Can I still access my medical information from previous patient portals?
Client Portal; Blog; Contact . Overland Hospital: 208.888.2910. Chinden Hospital: 208.888.2457. ... About IPH. Join Our Team. ... We feel privileged to provide world-class personalized veterinary care for every patient that comes through our doors. Overland Location (208) …
What is the PIH Health Good Samaritan patient portal?
Springfield: 217-52 4-DoIT (217-524-3648) Chicago: 312-81 4-DoIT (312-814-3648) Technical Support Week Days (8A-5P, Monday-Friday) Contact the IDPH Helpdesk at 866-220-5247 or via email at DPH.Helpdesk@illinois.gov for Portal access and web-based application support. Please include your name, phone number, and specific application name, detail ...

Before Your Appointment
Depending on the reason for your doctor’s visit, this checklist can help you prepare for an appointment with an Imperial Health physician:
Medical Records Inquiry
For a copy of your medical records, please call 337-312-8362 or fax a request to 337-312-6713.
Billing Inquiry & Billing Payment
To make a payment, live chat or to send an email, visit us at IMPH.PATIENTBILLHELP.COM.
Our Veterinarians
Owner with a special interest in minimally invasive surgery and ultrasound.
Veterinary Services
No one likes to see their pet sick or suffering. As longtime pet owners and animal lovers, Intermountain Pet Hospital's veterinarians and staff are dedicated to giving you the most thorough and comprehensive services to keep your pet happy and healthy.
Pet Lodge
Treat your dog to a day of fun at our safe and supervised daycare enrichment program. We'll spend time playing, exercising, and socializing your dog all day.
Who We Are
Our purpose is to bring happiness and good health into the lives of pets and people. We believe people live more healthier, longer, and more enriched and joyful lives with animals.
Your New Patient Portal is Here!
St. Peter's Health Partners has transitioned to a new patient portal – Trinity Health MyChart – to better meet your needs. Any new information from visits to a St. Peter's Health Partners doctor’s office or hospital from May 8 and beyond, including prescription refills, visit notes and lab results, will now be in your new MyChart patient portal.
New Patient Portal Coming Soon!
St. Peter's Health Partners is transitioning to a new patient portal – Trinity Health MyChart – in May 2021. After the transition, any new information, including prescription refills, visit notes and lab results, will be in your new MyChart patient portal.